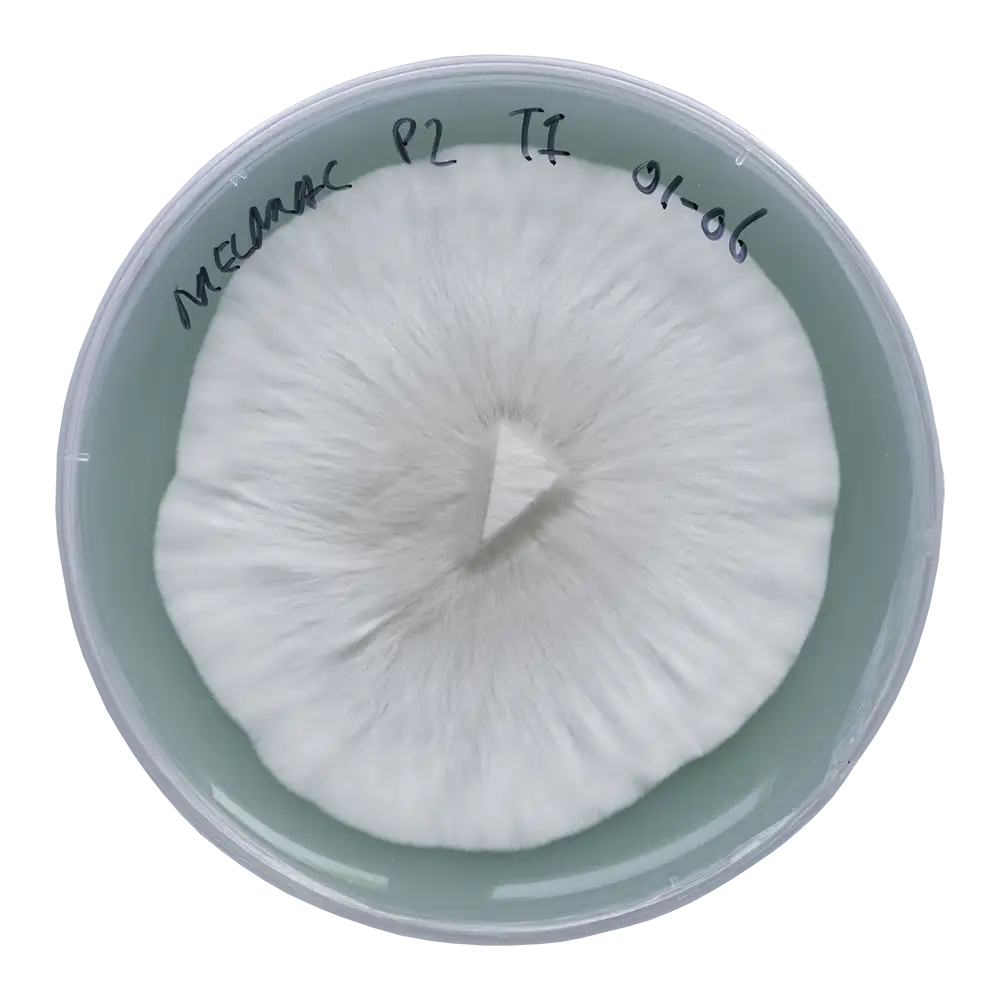

Setas mágicas Melmac Monster: orígenes y genética
Melmac Monster es una variante notable, cultivada en laboratorio, de la conocida y popular cepa Penis Envy, y podría considerarse un cultivar no oficial. Se rumorea que esta cepa lleva el nombre del planeta Melmac, de donde provenía ALF, el famoso personaje de la serie de televisión del mismo nombre. Las setas mágicas Melmac Monster son a menudo elogiadas por sus características «alienígenas» y su excepcional potencia.
Las setas suelen tener tallos gruesos, carnosos y retorcidos en tonos blancos, grises y amarillentos. Una característica de la genética leucística. Las esporas son de color púrpura oscuro a marrón y a menudo son viables. Sin embargo, cabe señalar que las setas mágicas Melmac Monster no producen grandes cantidades de esporas. Por lo tanto, se recomiendan hisopos de algodón estériles para una recolección adecuada.
El cultivo de esta cepa puede ser un poco más desafiante y es más adecuado para cultivadores con algo de experiencia. Debido a que la colonización y la fructificación pueden ser lentas, a menudo se requiere más paciencia y atención a las condiciones de cultivo adecuadas que con otras cepas de Psilocybe cubensis.
Desarrollo del cultivo líquido Melmac Monster
El desarrollo de nuestros cultivos líquidos Melmac Monster implicó un largo proceso de aislamiento y refinamiento. El primer paso fue obtener esporas viables. Una vez que las tuvimos, las germinamos en placas de agar y seleccionamos secciones de colonias de micelio sanas. Luego, inoculamos varias ollas de centeno esterilizado con estos s de micelio.
Una vez que el micelio colonizó completamente el sustrato de centeno, mezclamos el con sustrato CVG para estimular la fructificación. Luego, se clonó un espécimen prometedor en agar, seguido de múltiples transferencias de agar para lograr un cultivo puro y aislado. Finalmente, a través de algunos controles finales de calidad, nos aseguramos de que el producto final cumpliera con nuestros más altos estándares.
Aunque el proceso llevó mucho tiempo, estamos orgullosos de haber sido los primeros en poner a disposición un cultivo puro de Melmac Monster en Europa. Cada paso que hemos dado garantiza la calidad que todavía es claramente visible en nuestras jeringas de cultivo líquido hoy en día. Aunque Melmac Monster no es la cepa más sencilla de cultivar, estamos convencidos de que cualquiera que la pruebe quedará encantado con el resultado.
Contenido del producto
Cada jeringa Melmac Monster contiene 20 ml de micelio vivo en una solución nutritiva cuidadosamente formulada. La jeringa es un modelo B. Braun de alta calidad para una manipulación e inoculación precisas.
Además, el embalaje del producto contiene dos toallitas con alcohol isopropílico al 70%, una aguja de jeringa estéril de 16G y un folleto de instrucciones.
Cómo usar una jeringa de cultivo líquido Melmac Monster
Para obtener más información, consulta nuestros artículos sobre el uso de jeringas de cultivo líquido.
Precauciones de seguridad y manipulación
Al manipular la jeringa de cultivo líquido Melmac Monster, es fundamental seguir las precauciones de seguridad adecuadas para evitar la contaminación y garantizar un proceso de crecimiento exitoso. Aquí hay algunas pautas generales a tener en cuenta:
- Siempre manipule la jeringa en un ambiente limpio y estéril.
- Use guantes de nitrilo sin polvo y una mascarilla para evitar la contaminación.
- Asegúrese de que haya poco o ningún flujo de aire en su lugar de trabajo.
- Evite tocar la aguja o el cultivo líquido directamente para mantener la esterilidad.
- Guarde la jeringa en un refrigerador a 4-7°C para prolongar su vida útil.
Accesorios opcionales
Considere la posibilidad de utilizar una cabina de flujo laminar o una caja de aire quieto (SAB) para mayor esterilidad durante la inoculación de sustratos.
Datos generales
| Especie | Psilocybe cubensis |
| Genética | Penis Envy |
| Esporas | De color púrpura oscuro a marrón |
| Aplicaciones | Microscopía, investigación y propósitos de taxonomía. |
| Nivel de habilidad | Medio |
| Velocidad de colonización | Media |
| Potencia | alta |
Datos de cultivo
| Fase de desove | |
| Sustratos adecuados | Granos esterilizados como arroz integral, centeno, avena, mijo, palomitas de maíz o semillas para pájaros silvestres. |
| Tiempo de colonización | 9-14 días (tarro de litro lleno 2/3 / 27°C / agitado al 25-33% de colonización). |
| Temperatura | 25-27°C |
| Luz | Poca luz u oscuridad. |
| Fase de fructificación | |
| Sustratos adecuados | Estiércol, fibra de coco, CVG o paja (adecuadamente hidratados y tratados térmicamente). |
| Temperatura | 21-25°C |
| Humedad relativa | 80-100% |
| Intercambio de aire fresco (FAE) | Asegure un buen flujo de aire sin secar el sustrato. |
| Luz | Luz diurna indirecta o luz artificial suave (aproximadamente 6500 Kelvin). |
Notas
Este producto tiene una vida útil limitada y no es elegible para devolución. Para obtener más información, consulta nuestra página sobre el período de reflexión y las devoluciones.

Valoraciones
Aún no hay reseñas